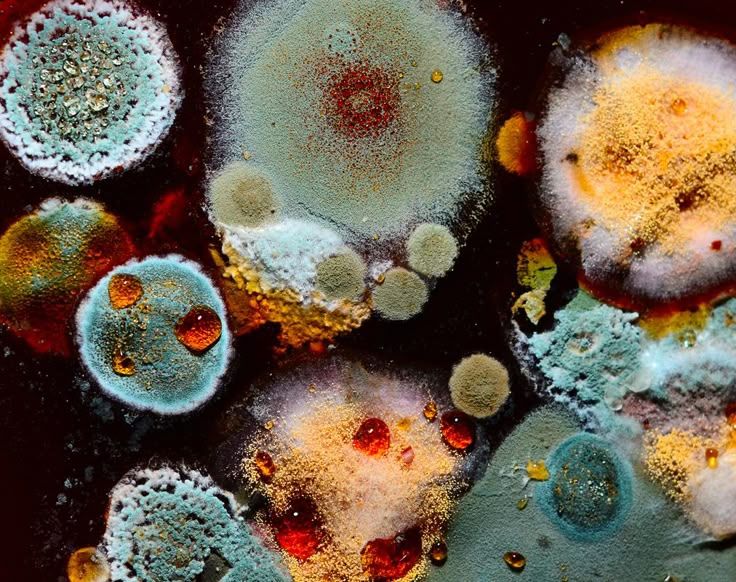

ezra
@fallowglen.bsky.social
ezra they/them '96
i will prob block u if u follow me and i don't know u!
hdr: walton ford pfp: repoghost
Earthstar Raindrop Ancient Harmony
🌧️🍄✨
i will prob block u if u follow me and i don't know u!
hdr: walton ford pfp: repoghost
Earthstar Raindrop Ancient Harmony
🌧️🍄✨
Pinned
ezra
@fallowglen.bsky.social
· Jun 2




i would go to school if THIS was the teacher and THIS was the uniform and THIS was the curriculum and THIS was the bus
Reposted by ezra
I don't remember who I was before I knew him

November 10, 2025 at 10:52 AM
I don't remember who I was before I knew him
Reposted by ezra
My best graphic tattoo designs from this year




November 9, 2025 at 7:22 PM
My best graphic tattoo designs from this year
Reposted by ezra
Reposted by ezra
today I learned fully about labouls, ectoparasitic fungi which are only found growing on live insects, but do not kill the host. they're just a kind of annoying small thingie that lives in the world and propagates

November 10, 2025 at 12:28 AM
today I learned fully about labouls, ectoparasitic fungi which are only found growing on live insects, but do not kill the host. they're just a kind of annoying small thingie that lives in the world and propagates
Reposted by ezra
bad news dude, they're on the Fighter Select screen selecting and deselecting you over and over to make fun of your voice line. they're saying the little pose you do when selected is wack. they're rotating you
November 11, 2024 at 7:27 AM
bad news dude, they're on the Fighter Select screen selecting and deselecting you over and over to make fun of your voice line. they're saying the little pose you do when selected is wack. they're rotating you
Reposted by ezra
European green crab

November 9, 2025 at 8:11 PM
European green crab
Reposted by ezra
gaming magazines used to be so true........

November 9, 2025 at 7:23 PM
gaming magazines used to be so true........
Reposted by ezra
i would go to school if THIS was the teacher and THIS was the uniform and THIS was the curriculum and THIS was the bus

June 2, 2025 at 11:01 PM
i would go to school if THIS was the teacher and THIS was the uniform and THIS was the curriculum and THIS was the bus
may start using my nsfw art alt as a general nsfw talk space or whatever...keep stuff separate. if u want the link u can dm me but dont be hurt if i refuse fgghfjfg i am shy
November 9, 2025 at 1:55 AM
may start using my nsfw art alt as a general nsfw talk space or whatever...keep stuff separate. if u want the link u can dm me but dont be hurt if i refuse fgghfjfg i am shy
Reposted by ezra
Reposted by ezra
that's where all this is from I think




November 8, 2025 at 10:45 PM
that's where all this is from I think
Reposted by ezra
Been singing this version of Nick Drake's River Man to myself alot
November 8, 2025 at 10:58 PM
Been singing this version of Nick Drake's River Man to myself alot
Reposted by ezra
I want a vintage curio shelf WHY are they all 100 dollars
November 5, 2025 at 9:38 AM
I want a vintage curio shelf WHY are they all 100 dollars
Reposted by ezra
this portion of zohrans victory speech genuinely brought tears to my eyes
November 5, 2025 at 7:02 AM
this portion of zohrans victory speech genuinely brought tears to my eyes
Reposted by ezra
i can’t believe a good thing happened we should do this more often
November 5, 2025 at 2:26 AM
i can’t believe a good thing happened we should do this more often
Reposted by ezra
Kate Bush, 1978 by music scene photographer Jill Furmanovsky #WomensArt

November 5, 2025 at 5:14 AM
Kate Bush, 1978 by music scene photographer Jill Furmanovsky #WomensArt
Reposted by ezra
BREAKING: every Republican has died
November 5, 2025 at 4:58 AM
BREAKING: every Republican has died
Why did no one tell me how transgender v for vendetta is
November 5, 2025 at 5:50 AM
Why did no one tell me how transgender v for vendetta is
Reposted by ezra
Reposted by ezra
Had the chance to illustrate for Quanta again, and got to draw one of my favorite animals: sharks! This is for “Shark Data Suggests Animals Scale Like Geometric Objects” by Joanna Thompson. It was really fun to focus on all sorts of species, from the large Whale Shark to the small Spiny Dogfish

November 3, 2025 at 3:04 PM
Had the chance to illustrate for Quanta again, and got to draw one of my favorite animals: sharks! This is for “Shark Data Suggests Animals Scale Like Geometric Objects” by Joanna Thompson. It was really fun to focus on all sorts of species, from the large Whale Shark to the small Spiny Dogfish
Reposted by ezra
it’s pretty funny there was a bush/dick presidential ticket. regardless of anything else the world can come together and admit that
November 4, 2025 at 3:36 PM
it’s pretty funny there was a bush/dick presidential ticket. regardless of anything else the world can come together and admit that
Reposted by ezra









